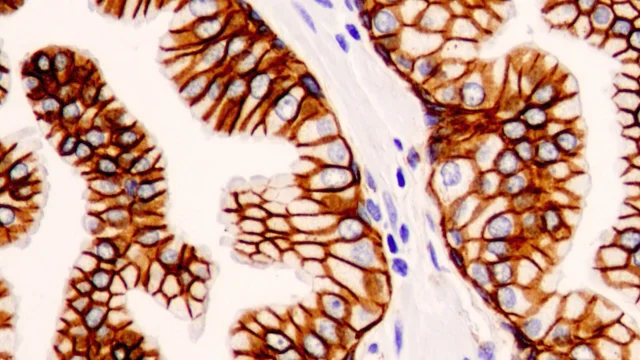

- シーンから探す
-
贈る相手から探す
- 彼氏
- 彼女
- 男友達
- 女友達
- 夫・旦那
- 妻・奥さん
- お父さん・父
- お母さん・母
- 両親
- おじいちゃん・祖父
- おばあちゃん・祖母
- 女性
- 男性・メンズ
- 妊婦
- 同僚
- 同僚(男)
- 同僚(女)
- 上司(男)
- 上司(女)
- 部下
- ビジネスパートナー・取引先
- 夫婦
- カップル
- 親友
- 女の子
- 子供
- 男の子
- 赤ちゃん・ベビー
- 乳幼児
- 1歳の誕生日プレゼント
- 2歳の誕生日プレゼント
- 3歳の誕生日プレゼント
- 4歳の誕生日プレゼント
- 5歳の誕生日プレゼント
- 6歳の誕生日プレゼント
- 7歳の誕生日プレゼント
- 8歳の誕生日プレゼント
- 9歳の誕生日プレゼント
- 10歳の誕生日プレゼント
- 18歳の誕生日プレゼント
- 19歳の誕生日プレゼント
- 20歳の誕生日プレゼント
- 21歳の誕生日プレゼント
- 22歳の誕生日プレゼント
- 25歳の誕生日プレゼント
- 26歳の誕生日プレゼント
- 30歳の誕生日プレゼント
- 40歳の誕生日プレゼント
- 50歳の誕生日プレゼント
- 60歳の誕生日プレゼント
- 70歳の誕生日プレゼント
- 80歳の誕生日プレゼント
- 88歳の誕生日プレゼント
- 90歳の誕生日プレゼント
-
カテゴリから探す
- 名入れギフト
- 記念品
- 文房具
- 花
- ビューティー
- こだわりグルメ
- ジュース・ドリンク
- お酒
- 絶品スイーツ
- ケーキ
- お菓子
- プリン
- フルーツギフト
- リラックスグッズ
- アロマグッズ
- コスメ
- デパコス
- インテリア
- キッチン・食器
- グラス
- 家電
- ファッション
- アクセサリー
- バッグ・ファッション小物
- ブランド腕時計(メンズ)
- ブランド腕時計(レディース)
- ベビーグッズ
- キッズ・マタニティ
- カタログギフト
- 体験ギフト
- 旅行・チケット
- ダレスグギフト
- ペット・ペットグッズ
- 面白い
- 大人向けのプレゼント
- 贅沢なプレゼント
- その他ギフト
- プレゼント交換
- 絆ギフト券プロジェクト
- リモート接待・5000円以下
- リモート接待・8000円以下
- リモート接待・10000円以下
- リモート接待・10000円以上
- おまとめ注文・法人のお客様
[A11151771]組織細胞化学 2019―第44回組織細胞化学講習会 組織細胞化学の基礎と応用:分子を観る、細胞を知る、機能を探る 日本組織細胞化
-
商品説明・詳細
-
送料・お届け
商品情報
組織細胞化学 (2023) | 日本組織細胞化学会 |本 | 通販 | Amazon,第49回組織細胞化学講習会,日本組織細胞化学会 - Japan Society Histochemistry and Cytochemistry,細胞培養・組織培養の技術 第4版|朝倉書店,免疫組織化学染色 (IHC) の基礎 | Cell Signaling Technology
残り 1 点 7349円
(3 ポイント還元!)
翌日お届け可(営業日のみ) ※一部地域を除く
お届け日: 04月27日〜指定可 (明日12:00のご注文まで)
-
ラッピング
対応決済方法
- クレジットカード
-

- コンビニ前払い決済
-

- 代金引換
- 商品到着と引き換えにお支払いいただけます。 (送料を含む合計金額が¥299,000 まで対応可能)
- ペイジー前払い決済(ATM/ネットバンキング)
-
以下の金融機関のATM/ネットバンクからお支払い頂けます
みずほ銀行 、 三菱UFJ銀行 、 三井住友銀行
りそな銀行 、ゆうちょ銀行、各地方銀行 - Amazon Pay(Amazonアカウントでお支払い)
-

![[A11151771]組織細胞化学 2019―第44回組織細胞化学講習会 組織細胞化学の基礎と応用:分子を観る、細胞を知る、機能を探る 日本組織細胞化](https://auctions.c.yimg.jp/images.auctions.yahoo.co.jp/image/dr000/auc0502/users/d4fab30473777a8019148ae00533fa27693af6d4/i-img300x427-1708118556a1vryr453791.jpg)

![[A01525393]医療用具の臨床試験―その実践的ガイダンス [単行本] NancyJ. Stark; 晃忠, 中村](https://auctions.c.yimg.jp/images.auctions.yahoo.co.jp/image/dr000/auc0502/users/d4fab30473777a8019148ae00533fa27693af6d4/i-img357x500-1708107206fwnr5h453791.jpg)
![[A11010346]消化器腹腔鏡下手術 体位固定機械だし外回り DVD+学習テキスト 山本徹](https://auctions.c.yimg.jp/images.auctions.yahoo.co.jp/image/dr000/auc0503/users/d4fab30473777a8019148ae00533fa27693af6d4/i-img358x500-1710129539hcypcm912978.jpg)
![[A11075692]別冊医学のあゆみ 最新 うつ病のすべて 2010年 [雑誌] (別冊「医学のあゆみ」) 樋口輝彦](https://auctions.c.yimg.jp/images.auctions.yahoo.co.jp/image/dr000/auc0412/users/d4fab30473777a8019148ae00533fa27693af6d4/i-img354x500-1703520314pjvlyx250493.jpg)
![[A12046012]股関節・骨盤の画像診断](https://auctions.c.yimg.jp/images.auctions.yahoo.co.jp/image/dr000/auc0504/users/d4fab30473777a8019148ae00533fa27693af6d4/i-img321x500-1714047930udogjt212021.jpg)
![[A01100482]受精と着床 (新女性医学大系) [単行本] 雄二,武谷、 武志,麻生、 志朗,野沢、 敏博,青野; 仁雄,中野](https://auctions.c.yimg.jp/images.auctions.yahoo.co.jp/image/dr000/auc0503/users/d4fab30473777a8019148ae00533fa27693af6d4/i-img342x475-1710129561cirxkk906850.jpg)
![[A12270041]アトラス骨・関節画像診断 6](https://auctions.c.yimg.jp/images.auctions.yahoo.co.jp/image/dr000/auc0503/users/d4fab30473777a8019148ae00533fa27693af6d4/i-img354x500-1710461974feci8j4134.jpg)
![[A12232263]体表解剖と触診スキル デイヴィッド・バイフィールド、 スチュアート・キンシンガー; 山根 悟](https://auctions.c.yimg.jp/images.auctions.yahoo.co.jp/image/dr000/auc0503/users/d4fab30473777a8019148ae00533fa27693af6d4/i-img366x500-1710129644p8yywz878101.jpg)
![[A01173144]咬合性外傷の早期診断と治療法―顎態からのアプローチ 野田 隆夫](https://auctions.c.yimg.jp/images.auctions.yahoo.co.jp/image/dr000/auc0503/users/d4fab30473777a8019148ae00533fa27693af6d4/i-img358x500-1710129267dydxrm606906.jpg)
限定300部 李朝 古文書 絵画 古地図](https://auctions.c.yimg.jp/images.auctions.yahoo.co.jp/image/dr000/auc0502/users/0578f60c21d518a2131569512b9c0cc02bcb2003/i-img1200x1138-1707991452zjfwfu25.jpg)






